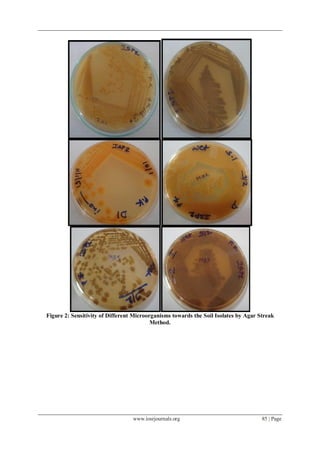
www.iosrjournals.org 85 | Page
Figure 2: Sensitivity of Different Microorganisms towards the Soil Isolates by Agar Streak
Method.

This document summarizes research that isolated and characterized antibiotic-producing microorganisms from waste soil samples collected from various industrial areas in India. Soil samples were collected and microbes were isolated using serial dilution and spread plating techniques. Isolates were screened for antibiotic production against other microbes using agar streak and plug methods. Two Bacillus isolates (R29 and B81) showed strong antifungal activity and were selected for further characterization. Biochemical and genetic tests identified R29 as Bacillus subtilis and B81 as likely Bacillus subtilis or Bacillus licheniformis. The research aims to discover new antibiotics and contributes to understanding antibiotic-producing microbes isolated from industrial waste soils.

![www.iosrjournals.org 81 | Page
The diversity of soil microorganisms were of great significance as a factor promoting the early
discovery of antibiotics [1]. Many types of microorganisms such as moulds, bacteria, protozoa and algae, all
competing for limited nutrients in the soil, have to devise strategies to survive. Among these microbes are
autotrophs, free living nitrogen fixers, thermopiles, acidophiles, pathogens and saprophytes [1]. Natural product
antimicrobials have been used for centuries by native peoples all around the world, but it wasn’t until the late
1800s that people began to search for single compounds that could be used to kill disease causing bacteria. Soil
and plants had been used to prevent wounds from becoming infected or to treat rashes as far back as the Roman
and Byzantine empires. All cultural groups have medicinal folklore that has some level of effectiveness for any
number of ailments. Many modern common therapeutic agents have their origins in natural sources, such as:
Paclitaxel, also known as Taxol, which was derived from the yew tree Morphine, is derived from the opium
poppy; Atropine comes from the belladonna leaf; and Aspirin is from white willow bark [1].
The actinomycetes yielded about 70 % of these, and the remaining 30 % are products of filamentous
fungi and non-actinomycete bacteria [2-5]. Most of the bioactive compounds from actinomycete sort into
several major structural classes such as amino glycosides (e.g., streptomycin and kanamycin), ansamycins (e.g.,
rifampin), anthracyclines (e.g., doxorubicin), b-lactam (cephalosporins), macrolides (e.g., erythromycin), and
tetracycline. The objectives of this experiment were to survey for antibiotic-producing bacteria found in soil and
isolate and characterize antibiotics produced by soil-borne bacteria. Putative antibiotic-producing bacteria were
isolated from soil and antibiotic production was confirmed. It was hypothesized that antibiotic-producing
bacteria would be of the genera Bacillus or Streptomyces and that the antibiotics would be peptides that
inhibited the growth of Gram-positive bacteria [6-9]. The first truly effective class of antimicrobial drugs was
the sulfonamides, discovered by Gerhard Domagk. In 1932, two scientists at the Bayer Company, Mietzsch and
Klarer, synthesized Prontosil red, a red dye bound to a sulfonamide group. Domagk showed, in 1935, that
infections in mice caused by hemolytic streptococci were cured by Prontosil red [10, 11]. Unfortunately for
Bayer, Prontosil red was shown to have no antibacterial activity in vitro. This lack of activity was explained by
several researchers [12-18] showing that Prontosil red is split in vivo into its component dye and sulfanilamide,
the active antibacterial agent and a previously described molecule that was already in the public domain. From
that point, sulfanilamide was manufactured by a number of companies and work was begun to modify the
molecule to enhance performance, leading to decreased side effects and a broader spectrum of action.
II. Materials And Methods
2.1: Collections of soil samples from different places:
The soil samples were collected from in an around Dheradun, Industrial Areas Uttarakhand, India. The
soil samples were dried separately at 37o
C for 1 hour in hot air oven. Then they were cooled at room
temperature. 1 gm of each soil sample was added to a conical flask containing 100 ml of sterile water and few
drops of Tween-80 solution. All flasks were shaken for 30 minutes in orbital shaker incubator at 270
C. These
flasks were considered as stock cultures.
2.2: Isolation of Microbes:
The sample is mixed with 1L pure water to make solution sample. This solution sample is diluted up to
10-5 serial dilution. Serial dilution is a process of diluting a sample several times. The sterile Petri dish is label.
Than 90ml of phosphate buffer is transferred into each of 5 tubes using sterile pipettes (10ml) with aseptic
technique. By using sterile pipette (1ml), 1ml of water sample is transferred into 10-1 tube. Mix the test tube
properly. Continue dilution with aseptic technique for test 10-2 until 10-5. After that each of serial dilution is
transferred into nutrient agar plate by using spread plate method. 0.1ml of an appropriately diluted culture is
spread over the surface of agar using sterile glass spreader. The plate is then incubated until the colonies appear.
It is important that the surface of the plate be fairly dry so that the spread liquid soaks in.
2.3: Preliminary screening of crude antibiotic produced
Agar Streak Method: The microbial sensitivity of the soil isolates were analyzed by Agar streak method’. Each
of the isolate was streaked as a straight line on SBCD medium and incubated at 270
C for about 6 days After 6
days, different strains of microorganisms were streaked at right angle, but not touching to the streak and
incubated at 370
Cfor 24 hours in case of bacteria and 270
Cfor 48 hours in case of fungi. If, the organism is
sensitive against the antibiotic produced by actinomycetes, then it will not grow near the actinomyces [Table 1]..
Test of Microorganisms: The test bacteria that were used in this study include references, environmental as
well as clinical isolates. The typical reference strains were as follows:
Gram Positive Bacteria: Staphylococcus aureus , Streptococcus faecalis, Streptococcus pyogens, Bacillus
cereus, Acinetobacter calcaoceuticus.
Gram Negative Bacteria: Escherichia coli, Pseudomonas aeruginosa, Proteus vulgaris, Klebsiella pneumonia,
Bacillus subtilis.](https://image.slidesharecdn.com/o0568089-130502232405-phpapp02/85/O0568089-2-320.jpg)
![www.iosrjournals.org 82 | Page
Table 1:
Morphological and Cultural
Characterization:
Results (slant/butt) Symbol Interpretation
Red/yellow Alkaline reaction/ Acid
production
Glucose fermentation only;
Peptone catabolized
Yellow/yellow Acid production / Acid
production
Glucose and lactose and/or
sucrose fermentation
Red/red Alkaline reaction /
Alkaline reaction
No fermentation; Peptone
catabolized
Red/no color change Alkaline reaction / No
Change
No fermentation; Peptone used
aerobically
Yellow/yellow with
bubbles
Acid production / Acid
production, Gas
production
Glucose and lactose and/or
sucrose fermentation; Gas
produced
Red/yellow with bubbles Alkaline reaction / Acid
production, Gas
production
Glucose fermentation only;
Gas produced
Red/yellow with bubbles
and black precipitate
Alkaline reaction / Acid
production, Gas
production, H2S
Glucose fermentation only;
Gas produced; H2S produced
Red/yellow with black
precipitate
Alkaline reaction /
Alkaline reaction, H2S
Glucose fermentation only;
H2S produced
Yellow/yellow with
black precipitate
Acid production / Acid
production, H2S
Glucose and lactose and/or
sucrose fermentation; H2S
produced
No change/no change No Change No fermentation
Morphological Characterization:
Cultural Characterization: Morphological and cultural characters of the selected actinomycetes
strains were studied by inoculating the selected strain into sterile International Streptomycetes Project
(ISP) media like the media were sterilized and poured into sterile petridishes. After solidification of
the media, culture of the selected strain was streaked on the media surface by simple method
aseptically and incubated at 270
C for 7 days. Morphological characters such as colony characteristics,
type of aerial hyphae, growth of vegetative hyphae, fragmentation pattern, spore formation and nature
of fermentation were observed [Table 1].
* Tryptone – Yeast extract broth
* Oatmeal agar
* Inorganic salts – Starch Agar
* Glycerol – Aspargine Agar
* Peptone – Yeast extract agar
* Tyrosine Agar
* Carbon utilization agar
The media were sterilized and poured into sterile petridishes. After solidification of the media, culture
of the selected strain was streaked on the media surface by simple method aseptically and incubated at 270
C for
7 days. Morphological characters such as colony characteristics, type of aerial hyphae, growth of vegetative
hyphae, fragmentation pattern and spore formation were observed
III. Results And Discussion:
Isolation Results: The isolation process is a procedure of isolation the mixture of colonies to a single colony.
This process was done by using streaking method to obtain pure cultures. The soil’s sample was added with 1
Liter pure water to obtain solution sample before transferred into nutrient agar plate. It is important that the
numbers of colonies developing on the plates are not being too large. On crowded plates some cells may not
form colonies, and some colonies may fuse, leading to erroneous measurements. So, to obtain the appropriate
colony number, the samples need to be diluted. This solution samples were diluted up to 10-5. By using spread
plate method, the diluted samples were transferred into nutrient agar plate and the bacteria were grown on it.
From the observation, these samples take about three until four days to growth on the plate. Table 2 (A & B)
and Figure 1 show the growth of the bacteria on plate after 5 days.
Collection of soil samples and number of microbial strains & Actinomycetes in isolation plates:
The projection of aerial mass is well explained in Table 2 (A & B) and illustrated in Figure 1.](https://image.slidesharecdn.com/o0568089-130502232405-phpapp02/85/O0568089-3-320.jpg)

![www.iosrjournals.org 88 | Page
Figure 4 (A to I): Assimilation of Different Carbon Sources
IV. Concluding Remarks
Soil sediment samples collected from the Dehradun pharmaceutical companies were divided in to two
parts as wet sample and dry sample. Serial dilution of wet and dry was done the no of isolates from the dry
sample was more in number. Marine sediment samples are good for the isolation of actinomycetes; Goodfellow
and Hynes [12] reviewed the literature on isolation of actinomycetes from waste soil sediments and suggested
that the waste soil sediment may be valuable for the isolation of novel actinomycetes. 15 isolates of
actinomycetes was isolated from the samples. The characterization was done by the phenotypic characterization
and species affiliation by physiological and biochemical characteristics described by Das et al. [9].
The aerial mass colour of almost all strains were Whitish grey and only one strain D1 has shown yellow colour.
Recent reports [17, 18] further entail that white colour series of actinomycetes they were the dominant forms.
Colour series were also recorded in soil, morphological observation of colonial characteristics such as amount
and colour of vegetative growth, and the presence and colour of aerial mycelium and spores, and again the
presence of diffusible pigments are recorded for each strain studied colonial growth on agar plate [19-25].
Concluding substantial activities are concerning with cellulose, caseinase, amylase, lipase and gelitinase with
certain specific variations.](https://image.slidesharecdn.com/o0568089-130502232405-phpapp02/85/O0568089-9-320.jpg)
![www.iosrjournals.org 89 | Page
References
[1]. Arifuzzaman.M, Khatun.M.R and Rahman.H, (2011), Isolation and screening of actinomycetes from Sundarbans soil for
antibacterial activity, African Journal of Biotechnology Vol. 9(29), pp. 4615-4619.
[2]. Arora.A, Nain and J.K. Gupta, (2010), Solid-state fermentation of wood residues by Streptomyces griseus B1, a soil isolate, and
solubilization of lignins World Journal of Microbiology & Biotechnology (2005) 21: 303–308.
[3]. Arunachalam.R, Wesely.E.G, George.J and Annadurai, (2010). Novel Approaches for Identification of Streptomyces
noboritoensis TBG-V20 with Cellulase Production, Current Research in Bacteriology 3 (1): 15-26.
[4]. Baskaran, R, Vijayakumar, R and Mohan, P. M,(2011) Enrichment method for the isolation of bioactive actinomycetes from
mangrove sediments of Andaman Islands, India Malaysian Journal of Microbiology, Vol 7(1), 1-7.
[5]. Bentley SD, Chater KF, Cerdeno-Tarraga AM, Challis GL, Thompson NR, James KD, Harris DE, Quail MA, Kieser H,
Harper D,(2011), Complete genome sequence of the model actinomycete Streptomyces coelicolor A3(2) Nature. 417:141 147.
[6]. Berg, G., P. Marten and G. Ballin, (2010). Stenotrophomonas maltophilia in the rhizosphere of oilseed rape: Occurrence,
characterization and interaction with phytopathogenic fungi. Microbiol. Res., 151: 19-27.
[7]. Boettger, E.C. (2009), Rapid determination of bacterial ribosomal RNA Sequences by direct sequencing of enzymatically amplified
DNA. FEMS Microbiology Letters 65, 171-174.
[8]. Bredholt, H., Fjaervik, E., Jhonsen, G. and Zotechev, S. B. (2010). Actinomycetes from sediments in the Trondhein Fjrod,
Norway: Diversity and biological activity. Journal of Marine Drugs 6, 12-24.
[9]. Das,S, Lyla,P.S and Khan,S.A,(2009), Distribution and generic composition of culturable marine actinomycetes from the
sediments of Indian continental slope of Bay of Bengal Chinese Journal of Oceanology and Limnology Vol. 26 No. 2, 166-177.
[10]. Dhanasekaran, D, Selvamani,S , Panneerselvam.A and Thajuddin.N, (2009), Isolation and characterization of actinomycetes in
Vellar Estuary, Annagkoil, Tamil Nadu African Journal of Biotechnology Vol. 8 (17), 4159-4162.
[11]. Don L. Crawford,t,James M. Lynch, John,M. Whipps, And Margaret, A. OUSLEY(2009), Isolation and Characterization of
Actinomycete Antagonists of a Fungal Root Pathogen Applied and environmental Microbiology, 3899-3905.
[12]. Goodfellow, M and Haynes, (1984), Actinomycetes in marine sediments in Biological, biochemical and biomedical aspects of
actinem(eds.) Ortiz-ortiz, I.,L.F. Bjalil and V.Yakoleff, Academic Press, London.453-472.
[13]. Gurung.T.D, Sherpa.C, Agrawal. P.V and Lekhak.B, (2010),Isolation and Characterization of Antibacterial Actinomycetes from
Soil Samples of Kalapatthar, 173 182.
[14]. Hong.K, Gao.A.H, Xie.Q,Y, Gao.H, Zhuang.L, Lin.H.P, Yu.H.P, LI.J, Yao.X.S, (2010), Actinomycetes for Marine Drug
Discovery Isolated from Mangrove Soils and Plants in China, licensee Molecular Diversity Preservation International, Basel,
Switzerland, 7(1): 24–44.
[15]. Jeffrey, L.S.H, Sahilah , A.M, Son R, Tosiah S (2011). Isolation and screening of actinomycetes from Malaysian soil for their
enzymatic and antimicrobial activities , Journal of Tropical Agriculture and Food Sciences. 35: 159-164.
[16]. Jensen, P. R., Gontang, E., Mafnas, C., Mincer, T. J. and Fenical, W. (2005).Culturable marine Actinomycetes diversity from
tropical Pacific Ocean sediments. Applied and Environmental Microbiology 7, 1039-1048.
[17]. Kumar,S.V, Sahu, M.K and Kathiresan .K (2005), Isolation and characterization of streptomycetes producing antibiotics from a
mangrove environment, Asian Jr. of Microbial. Biotech Env. Sc.Vol. 7 No. (3); 457-464.
[18]. Kumar.K.S, Haritha.R, Mohan.Y.S.Y.V and Ramana.T, (2011), Screening of marine Actinobacteria for Antimicrobial
Compounds, Research Journal of Microbiology 6(4): 385-393.
[19]. Lakshmipathy.D and Kannabiran.K, (2010), Isolation and Characterization of Antagonistic Actinomycetes from Marine Soil,
Journal of Microbial & Biochemical Technology, 2(1) : 001-006.
[20]. Lechevalier. M.P. and. Lechevalier.H.A, (2008). Procedures for studying and characterizing actinomycetes with emphasis on
streptomycetes. Part III. A university laboratory approach (emphasis on generic characterization). In: Actinomycete Taxonomy
(Dietz, A. and D.W. Thayer. eds.), 225-291.
[21]. Lechevalier. M.P., Prauser.H, Labeda.D.P, Ruan.J.S and Lechevalier. H.A. (2010). Two new genera of nocardioform
actinomycetes: Amyco/ata gen. nov. and Amyco/atopsis gen. nov. Int. J. Syst. Bacteriol. 36:29-37.
[22]. Mincer TJ, Jensen PR, Kauffman CA, Fenical W, (2009), Widespread and persistent populations of a major new marine
actinomycete taxon in ocean sediments. Appl Environ Microbiol , 68: 5005-5011.
[23]. Nathan A. Magarvey, Keller.J.M, Bernan.V, Dworkin.M, and Sherman.D.H, (2008), Isolation and Characterization of Novel
Marine-Derived Actinomycete Taxa Rich in Bioactive Metabolites Appl Environ Microbiol; 70(12): 7520–7529.
[24]. Pandey A, Shukla A, Majumdar SK (2009). Utilization of carbon and nitrogen sources by Streptomyces kanamyceticus M27 for
the production of an anti bacterial antibiotic. Afr. J. Biotechol. 4: 909-910.
[25]. Satheeja Santhi.S, Jose.A, and Solomon.J, R.D (2010), Isolation and Characterization of antagonistic actinomycetes from
Mangrove sediments, International Journal of Current Research, 3: 020-023.](https://image.slidesharecdn.com/o0568089-130502232405-phpapp02/85/O0568089-10-320.jpg)